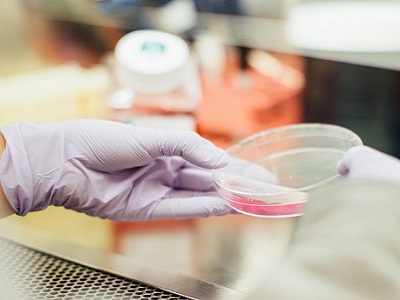
course thumb

Facilities

Professional Teachers
The school has a dedicated team of staff and educators who identify and nurture each individual's intelligence and abilities, bringing them to light for everyone, including the students themselves, to see.

Computer Labs
The School is well equipped with modern computing facilities for students and teachers. Its information technology based learning solutions, multimedia experience , e- resources and high speed internet connectivity are useful instruments for enhancing students overall knowledge and perspectives. The computer lab is like a resource centre for students and teachers. All the computer systems of the school are connected through high speed routers in form of LAN

Sports Facilities
The school provides an array of sports to develop the true spirit of sports manship among the students. Football ground, Cricket nets, Badminton courts, Basketball court, Skating Rink, Swimming pool, Tennis Court, Volley ball court and Sports room for Indoor games such as Chess, Table Tennis and Yoga are some of the games/sports that the school offers.

Library
To inculcate the love for reading the school has a well stacked library. It serves as the backbone of all academic activities of the school with sufficient no of Books, magazines etc. The educational Resource Centre library aims to promote reading and motivate learning. The School Library is open to all bonafide students of the school. All the classes are provided at least one library period every week.

Transport System
An efficient transport system that ensure safety of the children. Buses ply on pre-defined routes and be parked in the school premises so that alighting and boarding can be monitored by teachers personally.
Science Labs
To enable the students to hone their skills and learn the concepts practically, well equipped Physics, Chemistry, Biology labs. Students of all the senior classes visit the labs regularly and make extensive use of labs by performing experiments themselves, under the supervision of experienced faculty.

Language Labs
A language laboratory to impart a wholesome language learning experience to the students with the special emphasis on dramatics, elocution, presentations etc. proving true that a Children retain: 20% of what they hear, 40% of what they see, and 90% of what they do

Mathematics Laboratory
The Maths lab is a unique concept in the field of mathematics. It is a place where students can learn and explore various mathematical concepts and verify the facts and theorems using different activities. The lab is well equipped with necessary kits and tools. It provides an opportunity to the students to easily understand and internalize the basic mathematical concepts through concrete objects and situations.

Art & Craft
Art and craft room to sharpen their psycho motor skills and at the same time learn about artists like Picasso, Leonardo da Vinci, MF Hussain etc. They will also learn to take pride in what they create and even participate in in-house exhibitions to display their creations.